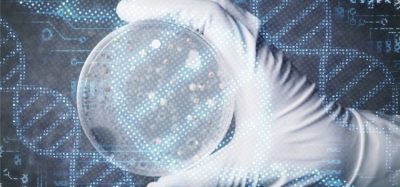

Infographic: Simplified bacterial endotoxin testing
Posted: 23 June 2021 | SUEZ | No comments yet
Endotoxin automation using microfluidics enables simpler, compliant processes for pharma QC, QA, validation and IT. BET assay setup is simplified and less LAL is required.
The Sievers Eclipse Bacterial Endotoxins Testing (BET) Platform uses microfluidic automation and the latest in compliant software to simplify each step of an endotoxin testing program, from supply chain and storage to validation, routine testing, and sign off. This infographic provides a summary of the areas within a pharmaceutical manufacturing facility which can benefit from the Sievers Eclipse BET Platform.
Related content from this organisation
Related topics
Analytical techniques, Biologics, Biopharmaceuticals, Bioprocessing, Biosimilars, Data integrity, Endotoxin, Environmental Monitoring, Excipients, Good Manufacturing Practice (GMP), Informatics, Ingredients, Lab Automation, Manufacturing, Medical Devices, Microbiology, Outsourcing, QA/QC, Regulation & Legislation, Research & Development (R&D), Supply Chain, Vaccines